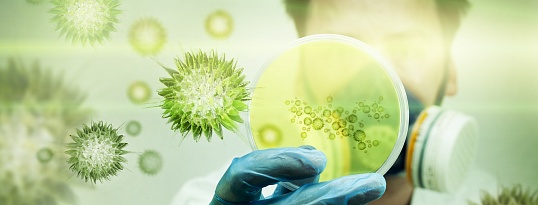

- Новости
- Главные новости
- Новости территориального отдела Управления Роспотребнадзора
- Новости Социального фонда России
- Новости Федеральной кадастровой палаты Росреестра
- Новости Инспекции ФНС
- Информация от государственных контрольно-надзорных органов МЧС
- Новости отделения надзорной деятельности и профилактической работы
- Проектная деятельность
- Профилактика коронавирусной инфекции
- Стратегия развития округа
- Городская среда
- ЖКХ
- Управление многоквартирными домами
- Капитальный ремонт многоквартирных домов
- Схема водоснабжения
- Схема теплоснабжения
- Городское управление жилищно-коммунального хозяйства
- Государственная информационная система жилищно-коммунального хозяйства
- Тарифы и нормативы потребления коммунальных услуг
- Качество питьевой воды
- Качество горячего водоснабжения
- Подключение к сетям инженерно-технического обеспечения
- Социальная газификация Свердловской области
- Перечень организаций, выполняющих работы по строительству сети газораспределения внутри земельных участков и внутридомовые работы в рамках догазификации
- Отопительный период
- Градостроительство
- Преимущества электронной формы обращения за получением муниципальных услуг по выдаче градостроительного плана земельного участка и разрешения на строительство
- Градостроительное зонирование
- Генеральный план
- Нормативы градостроительного проектирования
- Правила благоустройства
- Проекты планировки и межевания территории
- Список процедур, осуществляемых управлением архитектуры и градостроительства
- Предоставление разрешения на отклонение от предельных параметров разрешённого строительства, реконструкции объекта капитального строительства
- Реестр выданных разрешений на строительство объектов капитального строительства, ввод в эксплуатацию объектов капитального строительства
- Полезные ссылки
- Порядок установления причин нарушения законодательства о градостроительной деятельности
- Предоставление разрешения на условно разрешенный вид использования земельного участка или объекта капитального строительства
- Дорожное хозяйство, транспорт
- Экология
- Отлов и содержание собак без владельцев
- Имущество. Земля. Наружная реклама
- Мероприятия для повышение безопасности дорожного движения
- Перечень сведений, представленных с использованием координат
- Благоустройство, формирование комфортной городской среды
- Правила благоустройства Верхнесалдинского МО
- Реестр организаций, оказывающих ритуальные услуги
- Выявление правообладателей ранее учтенных объектов
- ЖКХ
- Всероссийская перепись населения 2020 года
- Антимонопольный комплаенс
- Экономика и финансы
- Коронавирус и антикризисные меры
- Национальные проекты
- Государственные программы
- Муниципальные программы
- Комплексные программы
- Доклады о достигнутых значениях показателей
- Социально-экономическое развитие города
- Майские указы Президента РФ
- Информация о занятости и безработице, территориальное трехстороннее соглашение
- Инфографика
- Предпринимательство
- Малое и среднее предпринимательство
- Новости
- Муниципальная программа
- Информация о количестве СМСП
- Информация о числе замещенных рабочих мест
- Информация об обороте товаров, работ, услуг
- Финансово-экономическое состояние СМСП
- Организации, образующие инфраструктуру поддержки СМСП
- Координационный совет по развитию предпринимательства
- Реестр СМСП
- Налоговая политика
- Государственная и муниципальная поддержка
- Перечень муниципального имущества для передачи
- Нормативно - правовая база
- Ежегодный план проведения плановых проверок
- Имущественная поддержка предпринимательства
- Потребительский рынок
- Проверки Финансового управления
- Мероприятия по повышению эффективности работы администрации
- Местные налоги
- Схема размещения нестационарных торговых объектов
- Оценка регулирующего воздействия
- Защита прав потребителей, финансовая грамотность
- Муниципальный контроль
- Нормативно-правовая база
- Программа профилактики нарушений
- Контроль за сохранностью автомобильных дорог
- Контроль соблюдения условий регулярных перевозок
- Муниципальный жилищный контроль
- Муниципальный лесной контроль
- Контроль в сфере благоустройства
- Муниципальный земельный контроль
- Доклад об осуществлении муниципального контроля
- Муниципальный контроль на автомобильном транспорте и в дорожном хозяйстве
- Организация выездной торговли на праздничных мероприятиях
- План организации и проведения ярмарок
- Инициативные проекты
- Специальный налоговый режим для самозанятых граждан
- Прилегающие территории
- Маркировка продукции
- Ведомственный контроль соблюдения трудового законодательства
- Итоги социологических опросов по оценке населением эффективности деятельности руководителей органов местного самоуправления
- Развитие конкуренции
- Охрана труда
- Бюджет
- Для бизнеса
- Социальная сфера
- Здравоохранение
- Обеспечение жильем
- Социальная политика
- Социальный фонд России
- Управление образования
- Учреждения культуры
- Спорт
- Городской совет ветеранов
- Молодежная политика
- Списки участников Великой отечественной Войны
- Люди с ограниченными возможностями здоровья
- Социально ориентированные некоммерческие организации
- Соблюдение законодательства в сфере доступной среды
- Инклюзивный туризм
- Администрация
- Глава Верхнесалдинского муниципального округа Свердловской области
- Положение об администрации ВСмо
- Аппарат администрации
- Административная комиссия
- Структурные подразделения
- Муниципальные предприятия и учреждения
- Управление социальной защиты населения
- Верхнесалдинские электрические сети
- МКУ "Служба субсидий"
- МКУ "Служба городского хозяйства"
- МКУ "Центр закупок"
- МКУ "Управление гражданской защиты"
- МУП "Центральная районная аптека № 42"
- МБУК "Централизованная библиотечная система"
- МКУ "Молодежный центр"
- МКУ "Централизованная бухгалтерия"
- МУП "Пассажиравтотранс"
- МБУ ДО "Центр детского творчества"
- МБУК "Верхнесалдинский краеведческий музей"
- МАУ ДО "Детская школа искусств Ренесанс"
- МАУК "Центр культуры, досуга и кино"
- МАУК "Кинотеатр Кедр"
- Информация о рассчитываемой за календарный год среднемесячной заработной плате
- Полномочия, задачи и функции
- Структура администрации
- Вакансии
- График приема граждан специалистами
- График работы администрации
- Общество
- Общественный совет
- Противодействие коррупции
- Общая информация
- Нормативные правовые и иные акты в сфере противодействия коррупции
- Антикоррупционная экспертиза
- Методические материалы
- Формы документов, связанных с противодействием коррупции, для заполнения
- Сведения о доходах, расходах, об имуществе и обязательствах имущественного характера
- Комиссия по соблюдению требований к служебному поведению и урегулированию конфликта интересов (аттестационная комиссия)
- Обратная связь для сообщения о фактах коррупции
- Антикоррупционное просвещение
- Комиссия по координации работы по противодействию коррупции
- Часто задаваемые вопросы
- Мнение о коррупции в округе
- Доклады, отчеты, обзоры, статистическая информация
- Правовые акты Финансового управления Администрации Верхнесалдинского муниципального округа Свердловской области в сфере противодействия коррупции
- Публичные слушания / Общественные обсуждения
- Общественные организации
- Религиозные организации
- Публичная декларация
- Бесплатная юридическая помощь
- Информация для участников принимавших (принимающих) в специальной военной операции, а также членов их семей
- Информация для иностранных граждан
- Общественная безопасность
- МКУ "Управление гражданской защиты"
- Общая информация
- Обеспечение мер пожарной безопасности
- Противопаводковые мероприятия
- Защита населения и территории от чрезвычайных ситуаций, безопасность людей на воде, льду
- Единая дежурно-диспетчерская служба
- Информация от государственных контрольно-надзорных органов МЧС Российской Федерации
- Нормативно-правовые акты Верхнесалдинского городского округа в области ГО, ЧС, пожарной безопасности, безопасности людей на воде
- База методических рекомендаций в области ГО, ЧС, пожарной безопасности, безопасности людей на воде
- Фото, видеоматериалы
- Противодействие коррупции
- Памятки населению о мерах безопасности
- Обстановка с пожарами
- Гражданская оборона
- Экстренные и штормовые предупреждения
- 9 пожарно-спасательный отряд ФПС ГНС ГУ МЧС России
- Верхнесалдинский таможенный пост
- Профилактика терроризма, минимизация и (или) ликвидация последствий его проявлений
- Антинаркотическая комиссия ВСмо
- Межведомственная комиссия по профилактике правонарушений
- Межведомственная комиссия по профилактике экстремизма
- Нижнетагильская межрайонная природоохранная прокуратура
- Отделение надзорной деятельности и профилактической работы
- Полиция
- Правовая информация прокуратуры
- МКУ "Управление гражданской защиты"
- Виртуальный учебно-консультационный пункт по гражданской обороне и чрезвычайным ситуациям
- Противодействие коррупции
- Общая информация
- Нормативные правовые и иные акты в сфере противодействия коррупции
- Антикоррупционная экспертиза
- Методические материалы
- Формы документов, связанных с противодействием коррупции, для заполнения
- Сведения о доходах, расходах, об имуществе и обязательствах имущественного характера
- Комиссия по соблюдению требований к служебному поведению и урегулированию конфликта интересов (аттестационная комиссия)
- Обратная связь для сообщения о фактах коррупции
- Антикоррупционное просвещение
- Комиссия по координации работы по противодействию коррупции
- Часто задаваемые вопросы
- Мнение о коррупции в округе
- Доклады, отчеты, обзоры, статистическая информация
- Правовые акты Финансового управления Администрации Верхнесалдинского муниципального округа Свердловской области в сфере противодействия коррупции
- Муниципальные услуги
- Перечень муниципальных услуг
- Анкета оценки качества муниципальных услуг
- Нормативно-правовая база
- Ответы на часто задаваемы вопросы по услугам
- Муниципальные услуги, доступные через портал Госуслуг
- Муниципальные услуги, не предоставляемые посредством комплексного запроса
- Преимущества получения услуг в электронном виде
- Как зарегистрироваться на портале госуслуг?
- Административные регламенты
- Услуги в цифрах
- Многофункциональный центр
- Досудебное обжалование
- Новости электронных услуг
- Необходимые и обязательные муниципальные услуги
- Видео-ролики
- Технологические схемы предоставления муниципальных услуг
- Вопросы в сфере градостроительной деятельности
- Обращения граждан
- Как обратиться в администрацию ВСмо
- Требования к обращениям граждан
- Правовые акты
- Прием граждан руководителями администрации
- Прием граждан специалистами администрации
- Обращения граждан в адрес Главы ВСмо
- Общероссийский день приема граждан
- Формы обращений, заявлений и иных документов
- Обращения из учреждений системы ФСИН
- Правовые акты
- О городе
- Салдинский Ветеран
- Сведения для распространителей информационной продукции, содержащей запрещенную для распространения среди детей информацию
- Общественные обсуждения по проекту изменений в Правила благоустройства территории Верхнесалдинского городского округа
- Общественные обсуждения проектной документации, включая материалы оценки воздействия на окружающую среду по объекту. Корпус травления титановых полуфабрикатов.
- Проведение общественных обсуждений Предварительных материалов оценки воздействия на окружающую среду объекта государственной экологической экспертизы регионального уровня – «Материалы, обосновывающие объемы (лимиты и квоты) добычи охотничьих ресурсов в Свердловской области, за исключением охотничьих ресурсов, находящихся на особо охраняемых природных территориях федерального значения в период с 1 августа 2026 года по 1 августа 2027 года
- Общественные обсуждения объекта государственной экологической экспертизы - проектной документации, содержащей материалы оценки воздействия на окружающую среду (ОВОС): «Блок усреднителей ОТР. Площадка слива. Цех 29»

Предотвращение распространения энтеровирусной инфекции среди населения
Энтеровирусные инфекции - группа инфекционных заболеваний человека, вызываемых энтеровирусами, имеющие весеннее - летнюю сезонность, поражающие преимущественно детское население и характеризующиеся лихорадкой, поражениями миндалин, центральной нервной системы, желудочно-кишечного тракта, кожными проявлениями и поражением других органов и систем.
С 2013 года показатели заболеваемости энтеровирусной инфекцией в Верхнесалдинском ГО превышают средне-областной уровень в 2-3 раза. По итогам 2015 года в Верхнесалдинском ГО переболели энтеровирусной инфекцией 3 жителя (показатель 6,3 на 100 тыс. населения), что в 3 раза больше 2014 года (1 случай ЭВИ, показатель - 2,1 на 100 тыс населения) и больше среднего многолетнего показателя (далее СМУ) (показатель 1,0 на 100 тыс. населения) и в 1,2 раза больше средне-областного уровня (показатель ССГ- 5,2 на 100 тыс. населения). В структуре ЭВИ - 100% занимают малые формы ЭВИ (герпангина, ЭВИ-лихорадка, ЭВИ-экзантема). Группой риска по заболеваниям ЭВИ были организованные дети в возрасте 0-2 года. В 2016 году занос энтеровирусной инфекции зарегистрирован в три детских дошкольных учреждения округа.
Учитывая высокие температурные показатели июня-июля 2016 года, активный купальный сезон, отсутствие организованных рекреационных зон купания, соответствующих требованиям санитарного законодательства, неблагоприятный прогноз заболеваемости ЭВИ на сезон 2016 года, связанный с распространением эпидемических вариантов вирусов Коксаки В6, ЕСНОЗО и активизацией циркуляции других энтеровирусов ЕСН011, летне-осеннюю сезонность ЭВИ, в августе 2016 года следует ожидать осложнение эпидемиологической ситуации по заболеваниям ЭВИ.
В целях предотвращения распространения энтеровирусной инфекции среди населения необходимо соблюдать правила личной гигиены, мыть овощи и фрукты перед едой, употреблять в пищу качественную воду, купаться в разрешенных местах, не заглатывать воду при купании и не контактировать с больными.
С 2013 года показатели заболеваемости энтеровирусной инфекцией в Верхнесалдинском ГО превышают средне-областной уровень в 2-3 раза. По итогам 2015 года в Верхнесалдинском ГО переболели энтеровирусной инфекцией 3 жителя (показатель 6,3 на 100 тыс. населения), что в 3 раза больше 2014 года (1 случай ЭВИ, показатель - 2,1 на 100 тыс населения) и больше среднего многолетнего показателя (далее СМУ) (показатель 1,0 на 100 тыс. населения) и в 1,2 раза больше средне-областного уровня (показатель ССГ- 5,2 на 100 тыс. населения). В структуре ЭВИ - 100% занимают малые формы ЭВИ (герпангина, ЭВИ-лихорадка, ЭВИ-экзантема). Группой риска по заболеваниям ЭВИ были организованные дети в возрасте 0-2 года. В 2016 году занос энтеровирусной инфекции зарегистрирован в три детских дошкольных учреждения округа.
Учитывая высокие температурные показатели июня-июля 2016 года, активный купальный сезон, отсутствие организованных рекреационных зон купания, соответствующих требованиям санитарного законодательства, неблагоприятный прогноз заболеваемости ЭВИ на сезон 2016 года, связанный с распространением эпидемических вариантов вирусов Коксаки В6, ЕСНОЗО и активизацией циркуляции других энтеровирусов ЕСН011, летне-осеннюю сезонность ЭВИ, в августе 2016 года следует ожидать осложнение эпидемиологической ситуации по заболеваниям ЭВИ.
В целях предотвращения распространения энтеровирусной инфекции среди населения необходимо соблюдать правила личной гигиены, мыть овощи и фрукты перед едой, употреблять в пищу качественную воду, купаться в разрешенных местах, не заглатывать воду при купании и не контактировать с больными.
 Официальный Сайт
Официальный Сайт